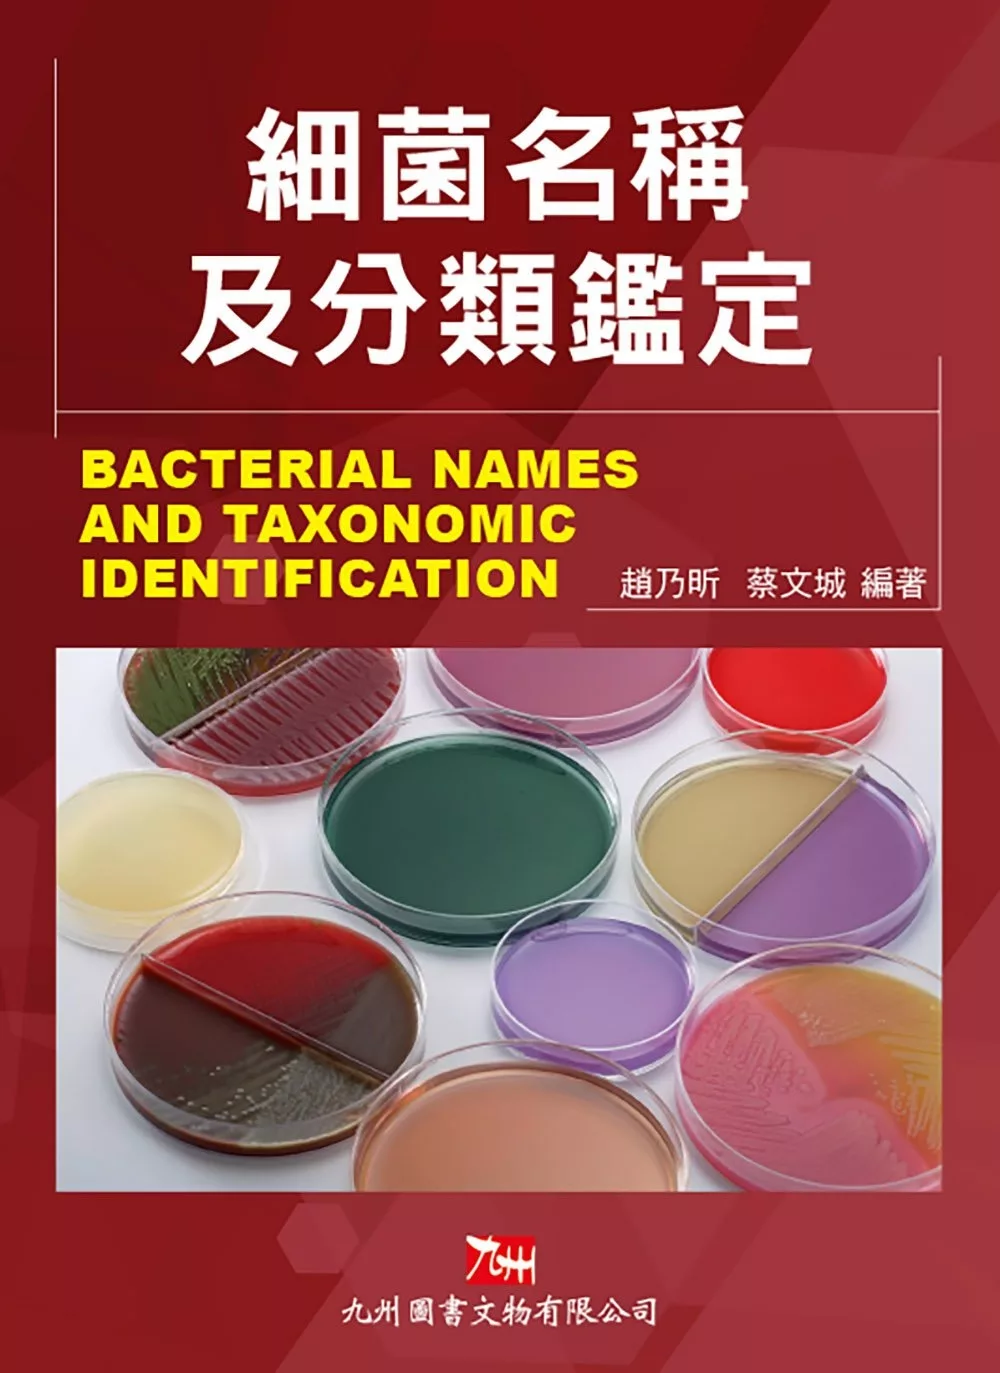

新書推薦-「細菌名稱及分類鑑定
閱讀心得,心得感想,書評
內容簡介
新版《細菌名稱及分類鑑定》一書,排列有序,查詢方便。本書編排順序基本上同第二版,以細菌菌屬的學名(即拉丁學名),按字母順序排列逐個菌屬的介紹,其內容主要有:每個菌屬的學名與中文名;發表此菌屬的原始文獻;菌屬的修正描述文獻;菌屬的定義性描述;菌屬中包括的菌種及拉丁學名與中文名對照,每個菌種的建種文獻(雜誌、年、卷、期、起止頁);最後是菌屬中菌種的表現型和鑑別特徵。新版《細菌名稱及分類鑑定》一書,資料充實,內容新穎。書中收集大量與人體、動物(哺乳動物)有關的病原菌、條件致病菌,對這些細菌特徵的鑑別都做了簡要論述,到目前已收集到的菌屬280個,菌種約4,000餘種,可供科研、教學、臨床醫學、獸醫學、檢驗學、疾病預防控制中心和公共衛生等單位應用和參考。此書包含一些常見菌,農業、工業、土壤、環境等學科也可能用到。
沒有留言:
張貼留言